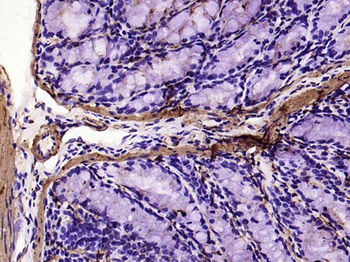
Alpha smooth muscle Actin Reco

产品描述:Alpha smooth muscle Actin Recombinant Rabbit Monoclonal Antibody
别名:alpha sarcomeric Actin; alpha smooth muscle Actin; Actin alpha; ASMA; ASM-A; alpha-SMA; alpha SMA; AAT6; ACTA2; Actin alpha 2 smooth muscle aorta; Actin aortic smooth muscle; ACTSA; ACTVS; alpha 2 actin; alpha cardiac actin; alpha-actin 2; Cell growth inhibiting gene 46 protein; Growth inhibiting gene 46; ACTA_HUMAN; Actin alpha 2 smooth muscle aorta; Actin aortic smooth muscle; Actin, aortic smooth muscle; alpha 2 actin; alpha actin 2; alpha cardiac actin; alpha-actin 2; alpha-actin-2; Cell growth inhibiting gene 46 protein; Cell growth-inhibiting gene 46 protein; Growth inhibiting gene 46; MYMY5
免疫原:A synthesized peptide derived from human Actin (1-30aa)
预测反应性:Zebrafish
克隆性:8C3
分子量:42 kDa
应用稀释比例:WB=1:2000-10000, IHC-P=1:200-800, IHC-F=1:200-800, ICC/IF=1:100-500, IF=1:200-800
防腐剂:0.01M TBS (pH7.4) with 1% rAlbumin, 0.02% Proclin300 and 50% Glycerol.
纯化:Affinity purified by Protein A
保存说明:Maintain refrigerated at 2-8°C for up to 2 weeks. For long term storage store at -20°C in small aliquots to prevent freeze-thaw cycles.
UniProt ID:P62736
Note:For research use only.
paraffin embedded (human cervical carcinoma), Antigen retrieval by boiling in sodium citrate buffer (pH6.0) for 15 min, Block endogenous peroxidase by 3% hydrogen peroxide for 20 minutes, Blocking buffer (normal goat serum) at 37°C for 30 min, Antibody incubation with (alpha smooth muscle Actin) Monoclonal Antibody, Unconjugated (orb704531) at 1:200 overnight at 4°C, followed by operating according to SP Kit (Rabbit) instructionsand DAB staining.
Fixative-fixed, paraffin embedded (human gastric), Antigen retrieval by boiling in sodium citrate buffer (pH6.0) for 15 min, Block endogenous peroxidase by 3% hydrogen peroxide for 20 minutes, Blocking buffer (normal goat serum) at 37°C for 30 min, Antibody incubation with (alpha smooth muscle Actin) Monoclonal Antibody, Unconjugated (orb704531) at 1:200 overnight at 4°C, followed by operating according to SP Kit (Rabbit) instructionsand DAB staining.
Fixative-fixed, paraffin embedded (mouse colon), Antigen retrieval by boiling in sodium citrate buffer (pH6.0) for 15 min, Block endogenous peroxidase by 3% hydrogen peroxide for 20 minutes, Blocking buffer (normal goat serum) at 37°C for 30 min, Antibody incubation with (alpha smooth muscle Actin) Monoclonal Antibody, Unconjugated (orb704531) at 1:200 overnight at 4°C, followed by operating according to SP Kit (Rabbit) instructionsand DAB staining.
Fixative-fixed, paraffin embedded (mouse uterus), Antigen retrieval by boiling in sodium citrate buffer (pH6.0) for 15 min, Block endogenous peroxidase by 3% hydrogen peroxide for 20 minutes, Blocking buffer (normal goat serum) at 37°C for 30 min, Antibody incubation with (alpha smooth muscle Actin) Monoclonal Antibody, Unconjugated (orb704531) at 1:200 overnight at 4°C, followed by operating according to SP Kit (Rabbit) instructionsand DAB staining.
Fixative-fixed, paraffin embedded (rat colon), Antigen retrieval by boiling in sodium citrate buffer (pH6.0) for 15 min, Block endogenous peroxidase by 3% hydrogen peroxide for 20 minutes, Blocking buffer (normal goat serum) at 37°C for 30 min, Antibody incubation with (alpha smooth muscle Actin) Monoclonal Antibody, Unconjugated (orb704531) at 1:200 overnight at 4°C, followed by operating according to SP Kit (Rabbit) instructionsand DAB staining.
Fixative-fixed, paraffin embedded (rat stomach), Antigen retrieval by boiling in sodium citrate buffer (pH6.0) for 15 min, Block endogenous peroxidase by 3% hydrogen peroxide for 20 minutes, Blocking buffer (normal goat serum) at 37°C for 30 min, Antibody incubation with (alpha smooth muscle Actin) Monoclonal Antibody, Unconjugated (orb704531) at 1:200 overnight at 4°C, followed by operating according to SP Kit (Rabbit) instructionsand DAB staining.
Fixative-fixed, paraffin embedded (rat uterus), Antigen retrieval by boiling in sodium citrate buffer (pH6.0) for 15 min, Block endogenous peroxidase by 3% hydrogen peroxide for 20 minutes, Blocking buffer (normal goat serum) at 37°C for 30 min, Antibody incubation with (alpha smooth muscle Actin) Monoclonal Antibody, Unconjugated (orb704531) at 1:200 overnight at 4°C, followed by operating according to SP Kit (Rabbit) instructionsand DAB staining.

Sample: Lane 1: Large intestine (Mouse) Lysate at 40 ug, Lane 2: Stomach (Mouse) Lysate at 40 ug, Lane 3: Uterus (Mouse) Lysate at 40 ug, Lane 4: Kidney (Mouse) Lysate at 40 ug, Lane 5: Small intestine (Mouse) Lysate at 40 ug, Lane 6: NIH/3T3 (Mouse) Cell Lysate at 30 ug, Lane 7: Stomach (Rat) Lysate at 40 ug, Lane 8: Uterus (Rat) Lysate at 40 ug, Lane 9: A549 (Human) Cell Lysate at 30 ug, Lane 10: Hela (Human) Cell Lysate at 30 ug, Lane 11: A431 (Human) Cell Lysate at 30 ug, Primary: Anti-alpha smooth muscle Actin (orb704531) at 1/1000 dilution, Secondary: IRDye800CW Goat Anti-Rabbit IgG at 1/20000 dilution, Predicted band size: 42 kD, Observed band size: 42 kD.

Tissue/Cell: HepG2 cell, 4% Fixative-fixed, Triton X-100 at room temperature for 20 min, Blocking buffer (normal goat serum) at 37°C for 20 min, Antibody incubation with (alpha smooth muscle Actin) monoclonal Antibody, Unconjugated (orb704531) 1:100, 90 minutes at 37°C, followed by a FITC conjugated Goat Anti-Rabbit IgG antibody at 37°C for 90 minutes, DAPI (blue) was used to stain the cell nuclei.
Tissue/Cell: U-87mg cell, 4% Fixative-fixed, Triton X-100 at room temperature for 20 min, Blocking buffer (normal goat serum) at 37°C for 20 min, Antibody incubation with (alpha smooth muscle Actin) monoclonal Antibody, Unconjugated (orb704531) 1:100, 90 minutes at 37°C, followed by a FITC conjugated Goat Anti-Rabbit IgG antibody at 37°C for 90 minutes, DAPI (blue) was used to stain the cell nuclei.

文献和实验
文献和实验 技术资料
技术资料









